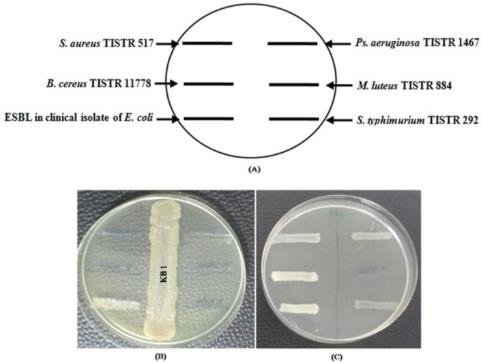

Int J Pharm Pharm Sci, Vol 7, Issue 11, 118-122Original Article
ANTIMICROBIAL AND CYTOTOXIC ACTIVITIES OF BIOACTIVE COMPOUNDS PRODUCED BY STREPTOMYCES SP. KB1
K. CHAWAWISIT1,3*, P. BHOOPONG1, W. PHUPONG2,3, M. LERTCANAWANICHAKUL1,3
1School of Allied Health Sciences and Public Health, Walailak University, Nakhon Si Thammarat 80161, Thailand, 2School of Sciences, Walailak University, Nakhon Si Thammarat 80161, Thailand, 3Utilization of Natural Products Research Unit, Walailak University, Nakhon Si Thammarat 80161, Thailand
Email: chawawisit@gmail.com
Received: 23 Aug 2015 Revised and Accepted: 22 Sep 2015
ABSTRACT
Objective: To investigate the antimicrobial and cytotoxic activities of bioactive compounds produced by Streptomyces sp. KB1 isolated from the air sample at Ao-nang, Krabi province, Thailand.
Methods: Streptomyces sp. KB1 was identified by 16S rDNA gene sequencing. It was preliminarily investigated the antibacterial activity by cross streak method and then cultivated in the half-formula of Luria Bertani at 30 °C, 200 rpm in shaking incubator for 7 d. Culture broth of each day was prepared as cell-free culture broth and tested the anti-Staphylococcus aureus TISTR 517 activity by agar well diffusion method along with determined the protein concentration by Bradford assay. Bioactive compounds were assessed the antimicrobial activity and cytotoxicity against brine shrimp by broth microdilution method and brine shrimp lethality bioassay, respectively.
Results: Bioactive compounds were excreted into liquid culture medium within 2 d of cultivation and showed a broad spectrum of antibacterial activity. Whereas, the highest activity has shown since day 4th of an incubation period which had protein concentration equal 254 ± 3.1 µg/ml. Bioactive compounds showed strong activity against Gram-positive bacteria, moderate activity against Gram-negative bacteria and weak activity against yeasts and Pseudomonas aeruginosa TISTR 1467. The MIC, MBC or MFC, and LC50 value of bioactive compounds were in the range of 0.49-63.50, 0.49-127.00, and 131.58 µg/ml, respectively.
Conclusion: This study implied that bioactive compounds produced by Streptomyces sp. KB1 may be the important polypeptide compound that can be used as lead compounds for novel drug discovery.
Keywords: Antimicrobial activity, Cytotoxic activity, Bioactive compounds, Streptomyces sp. KB1.
© 2016 The Authors. Published by Innovare Academic Sciences Pvt Ltd. This is an open access article under the CC BY license (http://creativecommons.org/licenses/by/4.0/)
INTRODUCTION
Currently, bioactive compounds have been studied worldwide due to they could be used as a model for development of novel or important medical agents [1]. With the discovery of bioactive compounds, one important source is microorganism especially terrestrial bacteria in the order actinomycetes [2]. Actinomycetes are Gram-positive bacteria that are widespread in nature. Among order actinomycetes, the members of the genus Streptomyces, is in the family Streptomycetaceae, are considered as important bioactive compounds producer because about 80% of total bioactive compounds that are used to develop as antibiotics, antifungal-, antitumoral-, antihelminthic-, antiviral-, immunomodulators-agents, herbicides and insecticides are produced by this genus [3, 4]. Streptomyces are chemoorganotrophic, non-fastidious, filamentous and aerobic bacteria, spore forming and non-motile with high G+C content (approximately 69-78%) in their DNA. They are free-living, saprophytic bacteria, widely distributed in soil, water and colonizing plants. In inappropriate environment, most Streptomyces usually produced secondary metabolites to kill or inhibit the growth of the related microorganisms [5]. Therefore, most of secondary metabolites were generally secreted outside the cell which often occurred at the late growth phase. Secondary metabolites that have such biological property were called as bioactive compounds. The temporal nature of bioactive compounds was controlled to synthesize by genetic biosynthesis, which was greatly connected with primary metabolism and influenced by environmental manipulation. Bioactive compounds, products of secondary metabolism, are low molecular (MW<3000 Da), chemically and taxonomically extremely diverse compounds which are not essential for normal growth, development or reproduction. From several medical problems, especially the old antibiotic resistance of pathogenic and/or opportunistic bacteria was continuously increasing [6]. As a result, the bioactive compounds were intensively studied to be possible for the development of new antibiotics [7]. Whereas, many bioactive compounds should not to develop as new antibiotic because it has cytotoxic activity, etc. Therefore, this study aims to investigate the antimicrobial and cytotoxic activities of bioactive compounds from Streptomyces sp. KB1 for possible evaluation that these bioactive compounds should be studied further in the future.
MATERIALS AND METHODS
Microorganisms, Media and cultural conditions
Producing strain: Streptomyces sp. KB1 was collected from the air sample at Ao-nang, Krabi province, Thailand, by using Biosampler, Microflow 90 (Aquaria, Italy), at flow rate 100 l/min for 30 min according to the manufacture’s instruction and isolated as pure culture on a half-formula of Luria Bertani (LB/2; Himedia, India) agar medium (5 g/l Tryptone, 2.5 g/l Yeast extract, 5 g/l NaCl and 15 g/l Agar powder). The isolate was identified by means of 16S rDNA gene sequence analysis at the National Center for Genetic Engineering and Biotechnology (BIOTEC), Pathum Thani province, Thailand, and published in the Gen Bank database (NCBI, USA). Later, it was cultured on LB/2 agar medium at 30 °C in static incubator (WTB binder, Germany) for 5 d. Single colony was inoculated into 10 ml of LB/2 broth medium in 25 ´ 150 mm of the screw cap test tube, incubated at 30 °C, 200 revolution per minute (rpm) in shaking incubator (Thermo scientific, USA) for 2 d or until the cells grown up to late logarithmic phase and stored in 15 % glycerol at-80 °C until use.
Indicator microorganisms:A total of 9 indicator microorganisms include representatives of Gram-positive bacteria viz. Bacillus cereus TISTR 11778, Micrococcus luteus TISTR 884 and Staphylococcus aureus TISTR 517, Gram-negative bacteria viz. Escherichia coli TISTR 887, Extended-spectrum Beta-lactamases (ESBL) in a clinical isolate of E. coli, Pseudomonas aeruginosa TISTR 1467 and Salmonella typhimurium TISTR 292 and yeasts viz. Candida albicans and Cryptococcus neoformans. Both representatives of Gram-positive and Gram-negative bacteria were cultured in LB agar medium at 37 °C in static incubator for 24 h. A single colony of each isolate was inoculated into 10 ml of LB broth medium in 25 ´ 150 mm of the screw cap test tube, incubated at 37 °C, 200 rpm in shaking incubator for 24 h. While, yeasts were cultured in Sabouraud Dextrose (SD) agar medium at 30 °C in static incubator for 48 h. After incubation, single colony of each representative of yeast was inoculated into 10 ml of SD broth medium in 25 ´ 150 mm of the screw cap test tube, incubated at 30 °C, 200 rpm in shaking incubator for 48 h. The cell of each indicator microorganism was stored in 15 % glycerol at-80 °C until use.
Antibacterial activity screening
Efficiency of bioactive compounds, produced by Streptomyces sp. KB1, was preliminarily investigated against indicator bacteria include B. cereus TISTR 11778, M. luteus TISTR 884, S. aureus TISTR 517, ESBL in a clinical isolate of E. coli, Ps. aeruginosa TISTR 1467 and S. typhimurium TISTR 292 by cross streak method [8]. Briefly, Streptomyces sp. KB1 was streaked as a line at the central position of the LB/2 agar plate about 0.6 ´ 7.5 cm and assigned as experimental plate. While, the unstreaked LB/2 agar plate was assigned as control plate. Both experimental and control plates were incubated at 30 °C in static incubator for 7 d.
After incubation, loopful of each freshly prepared indicator microorganism, adjusted turbidity with sterile normal saline solution equal to McFarland No. 0.5, was streaked on both experimental and control plates in the manner of perpendicular with the central line of Streptomyces sp. KB1 and then again incubated at 37 °C in static incubator for 24 h. The preliminary antibacterial activity was investigated by comparing the length of growth line of indicator bacteria between experimental and control plate.
Phylogenetic analysis
Almost complete sequence (1,445 bp) of the 16S rDNA gene was determined and compared with those of other closely related taxa retrieved from the Gen Bank database. Phylogenetic tree was constructed by the neighbor-Joining plot. A sequence similarity search was done using Gen Bank BLASTN (www. ncbi. nlm. nih. gov/blst). Sequences of closely related taxes were retrieved and aligned by means of the MEGA 4 program. For the neighbor-joining analysis, the distances between sequences were calculated using Kimura's two-parameter model. Bootstrap analysis was done to evaluate the confidence limits of the branching.
Cultivation of producing strain and preparation of cell-free culture broth
1 ´ 1 cm2 of initial streak of 5 d culture of Streptomyces sp. KB1 was inoculated to 25 ´ 150 mm screw cap test tube containing 10 ml of LB/2 broth medium. Inoculum was incubated at 30 °C, 200 rpm in the shaking incubator for 7 d. Every day, 100 µl of culture broth was harvested and centrifuged to separate the bacterial cell sediment at 4 °C, 12,000 rpm for 20 min. The supernatant was harvested and filtered through a 0.2 µm pore-size filter (Millipore, Germany) to remove residual bacterial cells by using aseptic technique. The received product was called as cell-free culture broth. Afterward, the cell-free culture broth was assessed anti-S. aureus TISTR 517 activity by agar well diffusion method [9] and measured the protein concentration by Bradford assay [10].
Minimum inhibitory concentration (MIC) assay
MIC value was determined by means of broth microdilution method [11]. The cell-free culture broth that showed significant highest anti-S. aureus TISTR 517 activity was diluted as 2-fold serial by Muller Hinton (MH) broth medium for indicator bacteria and SD broth medium for yeast in 96 well plates. The wells which contained 100 µl of the diluted cell-free culture broth were added 100 µl of 1.5 ´ 106 CFU/ml of indicator bacteria or yeast suspension and assigned as the experimental group. Well which had 100 µl of alone medium with 100 µl of 1.5 ´ 106 CFU/ml of indicator bacteria or yeast suspension was assigned as a control group. Both experimental and control groups were incubated at 37 °C for 24 h for indicator bacteria and 30 °C for 48 h for yeast in static incubator. The well with the least concentration of bioactive compounds showing no growth was taken as the MIC value for the respective microorganism.
Minimum bactericidal concentration (MBC) or Minimum fungicidal concentration (MFC) assay
The MBC or MFC value was determined by using subculture technique [11]. Briefly, 100 µl of each indicator microorganism cell suspension of well that showed MIC value and 3 wells with greater than the MIC value were spread on fresh MH or SD agar medium without antibiotic and incubated at 37 °C for 24 h for indicator bacteria or 30 °C for 48 h for yeast in static incubator. After incubation, if the growth of indicator bacteria and yeast were observed lower than 5 colonies, it indicated that the concentration of bioactive compounds of these well was MBC or MFC value.
Cytotoxicity bioassay
The cytotoxic activity of bioactive compounds was investigated by means of brine shrimp lethality bioassay [12]. In this method, the eggs of the brine shrimp, Artemia salina Leach, which kindly obtained from the faculty of Aquaculture Technology, School of Agricultural Technology, Walailak University, Nakhon Si Thammarat, Thailand, was hatched in artificial sea water (3.8 % NaCl solution) for 48 h to mature brine shrimp called nauplii (Larvae). Meanwhile, bioactive compounds were prepared by dissolving them into LB/2 broth medium to attain 500 µl of series concentrations of 225.00, 200.00, 175.00, 150.00, 127.00, 63.50, 31.75, 15.87, 7.94, 3.97, 1.98, 0.99, 0.49 and 0.25 µg/ml. 500 µl of LB/2 broth medium without bioactive compounds was assigned as the control vial. Both experimental and control vials were added 500 µl of 7.6 % NaCl solution to attain the final NaCl concentration of 3.8 %. Then 10 nauplii were applied to all experimental vials and control vial. The number of nauplii that died after 24 h was counted. The findings were graphically presented by plotting of bioactive compounds concentration versus percentage of mortality rate of nauplii from which LC50 was determined by extrapolation.
Statistical analysis
The obtained data were analyzed by using SPSS software version 17. One-way ANOVA (Analysis of Variance) was employed and the level of significance was P-value<0.05. Post-hoc turkey test was used to investigate the differences between the data.
RESULTS AND DISCUSSION
Selection and isolation of interesting isolate, KB1
After LB medium plate which was used to collect microorganisms from the air sample at Ao-nang, Krabi province, Thailand, was incubated at 30 °C in static incubator for 7 d. The embed colony, showed fungal-like formation, was isolated as pure culture by using aseptic technique for Gram staining. The isolate colony showed Gram positive branching formation, known as actinomycetes and named as KB1. Actinomycetes are the largest number of environmental microorganisms such as air, soil, water, mangrove sediment etc. [13]. From extensive studies in the past three decades, actinomycetes have been proven themselves as reliable sources of novel bioactive compounds and richest source of secondary metabolites [14].
Antibacterial activity screening
The isolate KB1 was preliminarily screened to produce the bioactive compounds and its antibacterial activity against indicator bacteria viz. B. cereus TISTR 11778, M. luteus TISTR 884, S. aureus TISTR 517, ESBL in a clinical isolate of E. coli, Ps. aeruginosa TISTR 1467 and S. typhimurium TISTR 292 by cross streak method. The cross-streaking is an easy and relatively rapid method for screening cultures in search for new antibiotics or bioactive compounds. This method, the isolate KB1 produced bioactive compounds and diffused into the agar around its swath. As a result, the inhibitory activity of the isolate KB1 could preliminarily screen against many indicator bacteria in one-time [8]. It was found that bioactive compounds, produced by the isolate KB1, showed a broad spectrum of antibacterial activity against both representative of Gram-positive bacteria (B. cereus TISTR 11778 and S. aureus TISTR 517) and Gram-negative bacteria (Ps. aeruginosa TISTR 1467 and S. typhimurium TISTR 292) but could not inhibit ESBL in a clinical isolate of E. coli. While, M. luteus TISTR 884 could not interpret results, because it is no grown both experimental and control plate (fig. 1). This finding indicated that the isolate KB1 could produce interesting bioactive compounds which might be develop as medicinal important agent in the future. Therefore, it was identified the genus and species in the later time.
Fig. 1: Preliminary antibacterial activity screening of the isolate KB1was investigated by comparing the length of growth line of indicator bacteria, illustrated in representative plate (A), between experimental plate (B) and control plate (C)
Phylogenetic analysis
After 16S rDNA gene amplification, the resulted sequence (approximately 1,445 bp) was subjected to similarity searches against public databases to infer possible phylogenetic relationship of the isolate KB1. The phylogenetic tree, which illustrated in fig. 2, indicated that the isolate KB1 should be placed in the genus Streptomyces. In the comparison of 16S rDNA gene sequences, the isolate KB1 was mostly related to S. varsoviensis NRRL B-3589T (98.89%), S. youssoufiensis X4T (98.68%) and S. ramulosus NRRL B-2714T (98.61%). While, Kitasatospora setae KM-6054T was used as an out-group. Based on the morphology and molecular phylogeny, the isolate KB1 was identified as genus Streptomyces and named as Streptomyces sp. KB1. The 16S rDNA gene sequence of Streptomyces sp. KB1 has been deposited in the GenBank database under the accession number KF939581.1.
Anti-S. aureus TISTR 517 activity and protein concentration of cell-free culture broth
Cell-free culture broth of each day was tested anti-S. aureus TISTR 517 activity and measured the protein concentration by agar well diffusion method and Bradford assay, respectively. It was found that Streptomyces sp. KB1 could produce bioactive compounds within 2 d of cultivation. Whereas, the highest significant activity was shown since day 4th of incubation period, which had the protein concentration equal 254 ± 3.1 µg/ml (P-value<0.05) (table 1). This experiment was performed to evaluate the best incubation period for bioactive compounds production and design the scale unit of them for interpreting results as quantitativeness. Surprisingly, it was found that Streptomyces sp. KB1 could fast produce bioactive compounds more than other Streptomyces which the most were in the range of 7-14 d of cultivation [15].
This surprising result might correlate with a decrease of nutritional value from LB to LB/2. Nevertheless, anti-S. aureus TISTR 517 activity of bioactive compounds that obtained from cultivating Streptomyces sp. KB1 both in LB and LB/2 broth medium did not differ significantly (P-value<0.05) (data not shown). These findings were supported by research of Monthon et al. Which reported that the best antimicrobial activity of Streptomyces lydicus A2 was seen by cultivating it in LB/2 broth medium and decrease in nutritional value from LB to LB/2 did not increase the number of inhibited test microorganism [16]. Moreover, this experiment also found that cell-free culture broth showed positive results after it was tested by the ninhydrin reaction which was assayed for detecting of protein or peptide. From these observing indicated that cell-free culture broth had composed of protein or peptide. Therefore, cell-free culture broth has been measured protein concentration and defined the scale unit as µg of protein/ml. Commonly, bioactive compounds which produced by genus Streptomyces had two major groups include (i) polyketide and (ii) polypeptide compounds [6]. The most were reported as polyketide compound [17]. Whereas in this study, it is possible that bioactive compounds might be as polypeptide compound similar to polypeptide antibiotic that produced by Streptomyces parvulus [18].
Table 1: Zone of inhibition and protein concentration of cell-free culture broth of each day
Incubation period (days) |
Zone of inhibition (mm)* |
Protein concentration (µg/ml)* |
1 |
0.00 ± 0.0 |
17 ± 2.2 |
2 |
20.33 ± 0.6 |
102 ± 6.3 |
3 |
21.67 ± 0.6 |
164 ± 6.7 |
4 |
23.67 ± 0.6 |
254 ± 3.1 |
5 |
23.67 ± 0.6 |
252 ± 8.7 |
6 |
23.67 ± 0.6 |
252 ± 1.0 |
7 |
23.33 ± 0.6 |
250 ± 3.9 |
* The data obtained from three triplicates and represented as mean ± SD.
Biological activities of bioactive compounds
Bioactive compounds were diluted as 2-fold serial dilution (0.25-127.00 µg/ml) for using in broth micro dilution method and prepared at different concentration levels from 0.25 to 225.00 µg/ml for using in brine shrimp lethality bioassay. In this experiment found that both MIC and MBC values of bioactive compounds against the representative of Gram-positive bacteria were in the range 0.49-0.99 µg/ml. For the representative of Gram-negative bacteria, MIC and MBC values of bioactive compounds were in the range 1.98-63.50 and 3.97-127 µg/ml, respectively. While, MIC and MFC values of bioactive compounds against yeasts were in the range 15.87-31.75 and equal to 63.50 µg/ml, respectively (table 2). From these finding indicated that bioactive compounds showed strongly inhibitory efficiency against Gram-positive bacteria, moderately inhibitory efficiency against Gram-negative bacteria and weakly inhibitory efficiency against yeasts including Ps. aeruginosa TISTR 1467 (P-value<0.05).
However, this result also indicated that bioactive compounds showed bactericidal or fungicidal activity against all indicator microorganisms which considered from MBC or MFC/MIC value of each indicator microorganism lower than or equal 4 (£ 4). Brine shrimp lethality bioassay, the effect of the bioactive compounds on the mortality rate of nauplii showed a concentration dependent activity (table 3). Protein concentration of bioactive compounds versus percentage of mortality rate of nauplii was plotted as a linear correlation graph. From this, a linear correlation graph could interpret 50 % lethal concentration (LC50) equal 131.58 µg/ml (fig. 3). When considering the LC50 value found that it was significantly higher than both MIC and MBC or MFC value (P-value<0.05). Therefore, this experiment demonstrated that bioactive compounds in cell-free culture broth had a weak cytotoxic activity against brine shrimp nauplii and also might be including to normal cells.

Fig. 2: The phylogram showing the position of the isolate KB1 with other Streptomyces based on 16S rDNA gene. Phylogenetic tree based on a neighbor-joining analysis of 1,000 resembled data. Number of nodes indicates the percent level of bootstrap support. The scale bar represents 0.005 substitutions per nucleotide position
Table 2: MIC and MBC or MFC values of bioactive compounds against each indicator microorganism
Indicator microorganisms |
MIC* value (µg/ml) |
MBC or MFC* value (µg/ml) |
Gram-positive bacteria |
||
B. cereus TISTR 11778 |
0.49 |
0.49 |
M. luteus TISTR 884 |
0.49 |
0.49 |
S. aureus TISTR 517 |
0.99 |
0.99 |
Gram-negative bacteria |
||
E. coli TISTR 887 |
3.97 |
7.94 |
Ps. aeruginosa TISTR 1467 |
63.50 |
127.00 |
S. typhimurium TISTR 292 |
1.98 |
3.97 |
Yeasts |
||
C. albicans |
15.87 |
63.50 |
C. neoformans |
31.75 |
63.50 |
* The data obtained from three triplicates and represented as the median.
Table 3: Percentage of the mortality rate of nauplii after exposing with bioactive compounds at different concentration levels for 24 h and LC50 value of bioactive compounds on nauplii
Protein concentration of bioactive compounds (µg/ml) |
The mortality rate of nauplii after exposed with bioactive compounds for 24 h. (%)* |
LC50 value (µg/ml) |
225.00 |
87.5 |
131.58 |
200.00 |
77.5 |
|
175.00 |
70.0 |
|
150.00 |
55.0 |
|
127.00 |
40.0 |
|
63.50 |
22.5 |
|
31.75 |
20.0 |
|
15.87 |
5.0 |
|
7.94 |
2.5 |
|
3.97 |
0.0 |
|
1.98 |
0.0 |
|
0.99 |
0.0 |
|
0.49 |
0.0 |
|
0.25 |
0.0 |
|
Control |
0.0 |
* The data obtained from three triplicates and represented as the average.

Fig. 3: Linear correlations between protein concentrations of bioactive compounds versus percentage of mortality rate of nauplii
CONCLUSION
The isolate described in this study was identified as novel species of genus Streptomyces and has been published in the Gen Bank database under the accession number KF939581.1. Small-scale liquid cultivation, LB/2 broth medium was used to produce bioactive compounds from this isolate. Bioactive compounds in cell-free culture broth which had a protein concentration of 254 ± 3.1 µg/ml showed MIC and MBC or MFC values on each indicator microorganism at different concentration levels in the range 0.49-63.50 and 0.49-127.00 µg/ml, respectively. When considering the LC50 value of bioactive compounds on nauplii which equaled 131.58 µg/ml found that it is significantly higher than both MIC and MBC or MFC values (P-value<0.05). This result demonstrated that these bioactive compounds have been interested and also might be as important polypeptide compound(s) that can be used as lead compound for development of novel polypeptide antibiotic in the future. Therefore, future our works will increase the yield of these bioactive compounds and then extract, purify and analyze the chemical structure of pure active compound including confirm the cytotoxicity in in vivo experiments.
ACKNOWLEDGEMENT
The author would like to thank associate professor Dr. Monthon Lertcanawanichakul for very good suggestions and the laboratory officer of the faculty of Aquaculture Technology, School of Agricultural Technology and faculty of Medical Technology, School of Allied Health Sciences and Public Health, Walailak University, Nakhon Si Thammarat, Thailand, for providing eggs of brine shrimp and facilities during this study. This research was supported by Walailak University Fund.
CONFLICTS OF INTERESTS
The author(s) have no declared any conflict of interests.
REFERENCES
- Berdy J. Bioactive microbial metabolites. J Antibiot 2005;58:1-26.
- Raja A, Prabakarana P. Actinomycetes and drug-an overview. Am J Drug Discovery Dev 2011;1:75-84.
- Watve MG, Tickoo R, Jog MM, Bhole BD. How many antibiotics are produced by the genus Streptomyces? J Arch Microbiol 2001;176:386-90.
- Rahman MA, Islam MZ, Khondkar P, Islam MA. Characterization and antimicrobial activities of a polypeptide antibiotic isolated from a new strain of Streptomyces parvulus. J Bangladesh Pharm 2010;13:14-6.
- Manasa M, Poornima G, Abhipsa V, Rekha C, Prashith KTR, Onkarappa R, et al. Antimicrobial and antioxidant potential of Streptomyces sp. RAMPP 065 isolated from kudremukh soil, Karnataka, India. Sci Technol Arts Res J 2012;1:39-44.
- Nandhini SU, Selvam MM. Antimicrobial compounds produced by Streptomyces strain. Int J Pharm Pharm Sci 2013;5:176-8.
- Procopio REL, Silva IR, Martins MK, Azevedo JL, Araujo JM. Antibiotics produced by Streptomyces. Braz J Infect Dis 2012;16:466-71.
- Lertcanawanichakul M, Sawangnop S. A comparison of two methods used for measuring the antagonistic activity of Bacillus Species. Walailak J Sci & Tech 2008;5:161-71.
- CLSI. Performance standards for antimicrobial susceptibility testing. Clinical and Laboratory Standards Institute; 2006. p. M100-S16.
- Bradford MM. A rapid and sensitive method for the quantitation of microgram quantities of protein utilizing the principle of protein dye binding. J Anal Biochem 1976;72:248-54.
- Yilmaz MT. Minimum inhibitory and minimum bactericidal concentrations of boron compounds against several bacterial strains. Turk J Med Sci 2012;42:1423-9.
- Solis PN, Wright CW, Anderson MM, Gupta MP, Phillipson JD. A micro-well cytotoxicity assay using Artemia salina (Brine Shrimp). J Plant Med 1992;59:250-2.
- Ahmad SJ, Lian HH, Basri DF, Zin NM. Mode of action of endophytic Streptomyces sp. SUK 25 extract against MRSA; Microscopic, Biochemical and Time-kill analysis. Int J Pham Sci Rev Res 2015;30:11-7.
- Lertcanawanichakul M. Isolation, phylogenetic characterization and antibacterial activity of Streptomyces strains isolated from the air at Walailak University. Int J Pharma Bio Sci 2015;6:1089-100.
- Hasani A, Kariminik A, Issazadeh K. Streptomycetes: characteristics and their antimicrobial activities. Int J Adv Biol Biomed Res 2014;2:63-75.
- Lertcanawanichakul M, Pondet K, Kwantep J. In vitro antimicrobial and antioxidant activities of bioactive compounds (secondary metabolites) extracted from Streptomyces lydicus A2. J Appl Pharm Sci 2015;5:17-21.
- Lorente A, Makowski K, Albericio F, Alvarez M. Bioactive marine polyketides as potential and promising drugs. Ann Marine Biol Res 2014;1:1-10.
- Shetty PR, Buddana SK, Tatipamula VB, Naga YVV, Ahmad J. Production of polypeptide antibiotic from Streptomyces parvulus and its antibacterial activity. Braz J Microbiol 2014;45:303-12.